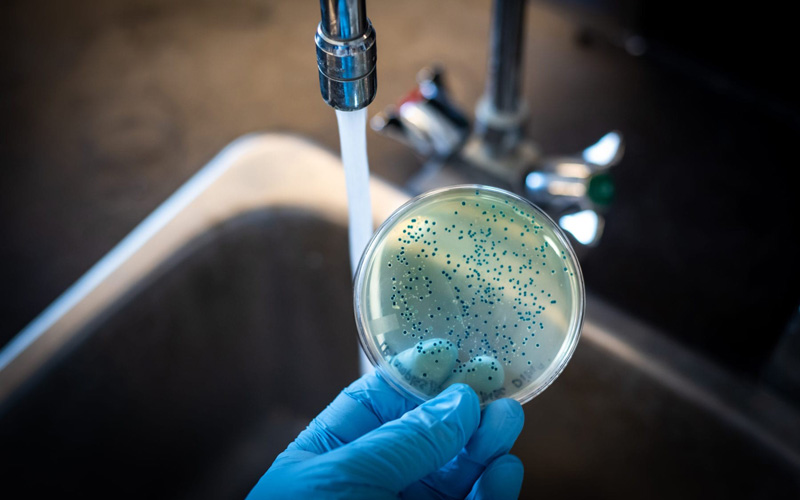

Vi khuẩn Coliform (coliform bacteria) là một nhóm vi sinh vật Gram âm, có hình dạng trực khuẩn, có khả năng sống hiếu khí hoặc yếm khí tùy nghi, không tạo bào tử và có đặc tính lên men lactose tạo acid và khí trong điều kiện nhiệt độ từ 35 – 37°C.
Nhóm vi khuẩn này phân bố rộng rãi trong tự nhiên, đặc biệt có mặt trong phân người và động vật máu nóng, đồng thời tồn tại trong đất, thảm thực vật và các nguồn nước ngọt.

Về bản chất, không phải tất cả vi khuẩn Coliform đều gây bệnh. Tuy nhiên, sự xuất hiện của Coliform trong nước sinh hoạt hoặc nước uống được xem là chỉ số quan trọng phản ánh mức độ ô nhiễm vi sinh.
Khi Coliform được phát hiện trong nguồn nước, điều đó cho thấy nguy cơ cao tồn tại đồng thời các tác nhân gây bệnh khác như vi rút, ký sinh trùng hoặc vi khuẩn gây bệnh nguy hiểm, ảnh hưởng trực tiếp đến sức khỏe con người.
Vi khuẩn Coliform được phân thành ba nhóm chính, dựa trên nguồn gốc và mức độ phản ánh tình trạng ô nhiễm của nguồn nước:
Là nhóm bao gồm toàn bộ các vi khuẩn Coliform có mặt trong môi trường tự nhiên như đất, thực vật và nước mặt. Nhóm này bao gồm nhiều chi vi khuẩn như Escherichia, Klebsiella, Enterobacter và Citrobacter.
Sự xuất hiện của Total Coliform cho thấy chất lượng vệ sinh chung của nguồn nước nhưng chưa khẳng định trực tiếp ô nhiễm phân.
Là nhóm con của Total Coliform, có khả năng sinh trưởng ở nhiệt độ cao từ 44,5 – 45,5°C và thường có nguồn gốc từ đường ruột của động vật máu nóng. Việc phát hiện Fecal Coliform trong nước là dấu hiệu rõ ràng cho thấy nguồn nước đã bị ô nhiễm phân.
Là loại Coliform đặc hiệu và nguy hiểm nhất, chỉ tồn tại trong đường ruột của động vật máu nóng, bao gồm con người.
E.coli được xem là chỉ số trực tiếp và chính xác nhất phản ánh tình trạng ô nhiễm phân tươi. Đặc biệt, một số chủng như E.coli O157:H7 có khả năng gây bệnh nghiêm trọng, ảnh hưởng trực tiếp đến sức khỏe con người.
Việc phân biệt rõ các nhóm vi khuẩn Coliform giúp đánh giá chính xác mức độ an toàn của nguồn nước và lựa chọn giải pháp xử lý phù hợp.
Chỉ số Coliform là thông số dùng để xác định sự hiện diện của vi khuẩn Coliform trong nước, qua đó đánh giá mức độ ô nhiễm vi sinh và mức độ an toàn đối với sức khỏe con người. Đây là một trong những chỉ tiêu quan trọng trong kiểm soát chất lượng nước sinh hoạt và nước uống trực tiếp.
Theo QCVN 01-1:2018/BYT, giới hạn cho phép đối với nước uống sinh hoạt được quy định:
Total Coliform: < 3 CFU/100 ml
E. coli: < 1 CFU/100 ml
Trong khi đó, QCVN 01-1:2024/BYT – tiêu chuẩn mới nhất – đã siết chặt yêu cầu khi quy định mức cho phép là < 1 CFU/100 ml (hoặc MPN/100 ml) cho cả Total Coliform và Thermotolerant Coliform.
Điều này cho thấy Việt Nam đang từng bước nâng cao tiêu chuẩn chất lượng nước sinh hoạt, hướng tới mục tiêu bảo vệ sức khỏe cộng đồng một cách toàn diện hơn.
Khi hàm lượng Coliform trong nước vượt mức quy định, điều này phản ánh các rủi ro nghiêm trọng sau:

Nguồn nước bị ô nhiễm vi sinh: Cho thấy khả năng cao có sự xâm nhập của phân người hoặc động vật vào nguồn nước.
Nguy cơ tồn tại mầm bệnh: Đồng nghĩa với việc nước có thể chứa các vi khuẩn gây bệnh, virus hoặc ký sinh trùng nguy hiểm, ảnh hưởng trực tiếp đến sức khỏe người sử dụng.
Hệ thống xử lý nước hoạt động không hiệu quả: Có thể xuất phát từ sai sót trong quá trình lọc, khử trùng hoặc do hệ thống đường ống, phân phối nước bị rò rỉ, tái nhiễm khuẩn.
Việc kiểm soát và duy trì chỉ số Coliform trong giới hạn cho phép là yêu cầu bắt buộc nhằm đảm bảo nguồn nước sinh hoạt an toàn, đạt chuẩn và bền vững.
Coliform là nhóm vi khuẩn không màu, không mùi, không vị, nên không thể nhận biết trực tiếp bằng cảm quan thông thường. Tuy nhiên, người sử dụng có thể phát hiện gián tiếp nguy cơ nhiễm Coliform thông qua một số biểu hiện sau:
Nước xuất hiện mùi lạ, mùi tanh hoặc mùi hôi bất thường.
Nước bị đục, đổi màu, không còn trong suốt như bình thường.
Sau khi sử dụng nước, cơ thể xuất hiện các triệu chứng như đau bụng, tiêu chảy.
Da bị kích ứng, ngứa hoặc khó chịu khi tiếp xúc với nước trong thời gian dài.
Nguồn nước sinh hoạt có thể bị nhiễm Coliform do nhiều nguyên nhân khác nhau, bao gồm cả yếu tố tự nhiên và tác động từ con người, cụ thể:

Nguồn nước ngầm bị ô nhiễm: Nước giếng khoan, giếng đào có nguy cơ bị thấm nhiễm từ bể phốt, khu chăn nuôi hoặc bãi chôn lấp rác thải. Thực tế tại Việt Nam cho thấy, nguồn nước giếng ở khu vực nông thôn có tỷ lệ nhiễm Coliform cao hơn đáng kể so với nước máy.
Hệ thống đường ống dẫn nước cũ, rò rỉ: Đường ống xuống cấp, nứt vỡ hoặc rò rỉ tạo điều kiện cho vi khuẩn từ đất và môi trường xung quanh xâm nhập trực tiếp vào nguồn nước.
Nguồn nước mặt bị ô nhiễm: Sông, hồ, ao chứa phân động vật và rác thải hữu cơ là môi trường lý tưởng cho Coliform phát triển, làm gia tăng nguy cơ ô nhiễm nguồn nước.
Bồn chứa nước không được vệ sinh định kỳ: Bể chứa, thùng chứa nước nếu không được làm sạch thường xuyên sẽ trở thành nơi vi khuẩn sinh sôi. Một nghiên cứu tại Thừa Thiên Huế cho thấy 25,7% mẫu nước trong thùng chứa trên thuyền có nhiễm E.coli.
Điều kiện khí hậu và môi trường: Mưa lớn, lũ lụt và ngập úng có thể cuốn theo phân động vật và rác thải vào nguồn nước. Tình trạng này đặc biệt nghiêm trọng tại khu vực nông thôn, vùng sâu, vùng xa, nơi điều kiện hạ tầng còn hạn chế.
Việc nhận diện sớm dấu hiệu và hiểu rõ nguyên nhân nhiễm Coliform là cơ sở quan trọng để chủ động kiểm soát chất lượng nước sinh hoạt, bảo vệ sức khỏe cho gia đình và cộng đồng.
Mặc dù không phải tất cả các chủng Coliform đều gây bệnh trực tiếp, tuy nhiên việc tiếp xúc và sử dụng lâu dài nguồn nước nhiễm Coliform có thể gây ra nhiều ảnh hưởng bất lợi đến sức khỏe.
Nhóm đối tượng chịu tác động rõ rệt nhất bao gồm trẻ nhỏ, người cao tuổi, phụ nữ mang thai và người có hệ miễn dịch suy giảm.
Gây rối loạn tiêu hóa: Việc sử dụng nước nhiễm Coliform có thể làm mất cân bằng hệ vi sinh đường ruột, dẫn đến các triệu chứng như đau bụng, đầy hơi, khó tiêu. Đối với người có hệ tiêu hóa nhạy cảm, đặc biệt là trẻ em, nguy cơ tiêu chảy và giảm khả năng hấp thu dinh dưỡng càng cao.
Ảnh hưởng đến hệ tiết niệu: Một số chủng Coliform, điển hình là E.coli, có khả năng xâm nhập vào đường tiết niệu khi tiếp xúc thường xuyên với nước nhiễm khuẩn. Tình trạng này có thể gây tiểu buốt, tiểu rát hoặc khó chịu khi đi tiểu, thường gặp hơn ở phụ nữ.
Suy giảm hệ miễn dịch: Sử dụng nguồn nước không đảm bảo vệ sinh trong thời gian dài khiến cơ thể phải liên tục đối phó với các tác nhân gây hại, từ đó làm suy giảm sức đề kháng tự nhiên. Người cao tuổi và phụ nữ mang thai dễ cảm thấy mệt mỏi, cơ thể nhạy cảm hơn với các yếu tố môi trường xung quanh.
Tích tụ nguy cơ ảnh hưởng lâu dài: Dù không gây tác hại tức thì, việc sử dụng nước nhiễm Coliform trong các sinh hoạt hằng ngày như rửa thực phẩm, đánh răng, tắm rửa có thể tạo điều kiện cho vi sinh vật phát triển, làm suy giảm chất lượng nguồn nước và ảnh hưởng tiêu cực đến sức khỏe theo thời gian.
.png)
Nhận thức đúng về tác hại của vi khuẩn Coliform là cơ sở quan trọng để người dân chủ động kiểm soát chất lượng nước sinh hoạt, từ đó bảo vệ sức khỏe cho bản thân và gia đình một cách bền vững.
Việc phát hiện sớm vi khuẩn Coliform trong nước sinh hoạt giúp người sử dụng chủ động áp dụng các biện pháp xử lý phù hợp, qua đó bảo vệ sức khỏe cho cả gia đình và hạn chế rủi ro lâu dài.
Hiện nay, trên thị trường có các bộ test nhanh Coliform và E.coli предназнач dành cho hộ gia đình, cho kết quả trong khoảng 24 – 48 giờ. Cách thực hiện tương đối đơn giản: người dùng lấy mẫu nước theo đúng hướng dẫn, cho thuốc thử vào mẫu và quan sát sự thay đổi màu sắc để xác định sự hiện diện của vi khuẩn.
Ưu điểm của phương pháp này là thao tác dễ, thời gian cho kết quả nhanh và chi phí thấp. Tuy nhiên, độ chính xác chỉ ở mức tương đối, không thay thế được xét nghiệm chuyên sâu, đồng thời chỉ phản ánh kết quả định tính (có hoặc không có vi khuẩn).
Phân tích tại phòng thí nghiệm là phương pháp tiêu chuẩn và có độ chính xác cao nhất hiện nay. Kết quả được xác định theo các chỉ số như MPN/100 ml (Most Probable Number) hoặc CFU/100 ml (Colony Forming Unit).
.png)
Thông qua xét nghiệm, người sử dụng có thể biết rõ nồng độ Total Coliform, E.coli cũng như các vi khuẩn khác như Pseudomonas aeruginosa. Từ đó, kết quả được đối chiếu với quy chuẩn QCVN 01-1:2024/BYT để đánh giá chính xác mức độ an toàn và chất lượng của nguồn nước sinh hoạt.
Việc lựa chọn phương pháp kiểm tra phù hợp, đặc biệt là xét nghiệm định kỳ tại phòng thí nghiệm, là cơ sở quan trọng để kiểm soát chất lượng nước, đảm bảo an toàn sức khỏe cho gia đình trong quá trình sử dụng lâu dài.
Để đảm bảo nguồn nước sinh hoạt an toàn, việc áp dụng các biện pháp xử lý và phòng ngừa nhiễm Coliform cần được thực hiện một cách chủ động, đúng kỹ thuật và phù hợp với điều kiện sử dụng thực tế.
Clo là phương pháp khử trùng được sử dụng phổ biến nhất hiện nay, có khả năng tiêu diệt phần lớn vi khuẩn Coliform. Theo QCVN 01-1:2024/BYT, nồng độ clo dư trong nước sau xử lý cần được duy trì trong khoảng 0,2 – 1,0 mg/L để đảm bảo hiệu quả khử khuẩn.
Tuy nhiên, việc sử dụng Clo đòi hỏi kiểm soát liều lượng nghiêm ngặt, bởi:
Nồng độ quá thấp (< 0,2 mg/L) không đảm bảo khả năng diệt khuẩn.
Nồng độ quá cao (> 2,0 mg/L) có thể tạo ra các hợp chất phụ như Trihalomethanes (THMs), tiềm ẩn nguy cơ ảnh hưởng đến sức khỏe.
Bên cạnh đó, Ozone cũng là một giải pháp khử trùng hiệu quả với khả năng diệt khuẩn mạnh và không để lại dư lượng hóa chất trong nước. Tuy nhiên, nhược điểm của phương pháp này là chi phí đầu tư và vận hành cao, thường phù hợp với các hệ thống xử lý nước quy mô lớn.
.jpg)
Đun sôi nước ở 100°C trong tối thiểu 1 – 3 phút có thể tiêu diệt hầu hết vi khuẩn Coliform và E.coli. Đây là biện pháp đơn giản, dễ thực hiện, phù hợp trong các trường hợp nước nhiễm khuẩn ở mức độ nhẹ hoặc sử dụng tạm thời.
Tuy nhiên, phương pháp đun sôi cũng tồn tại một số hạn chế:
Tốn thời gian và năng lượng.
Không loại bỏ được tạp chất hóa học và kim loại nặng có trong nước.
Chất lượng cảm quan của nước (mùi, vị) sau khi đun sôi có thể suy giảm.
Việc kết hợp các biện pháp xử lý phù hợp, đồng thời kiểm soát và bảo trì hệ thống cấp nước định kỳ, là giải pháp quan trọng để phòng ngừa nguy cơ nhiễm Coliform, đảm bảo an toàn cho sức khỏe người sử dụng trong sinh hoạt hằng ngày.
Máy lọc nước tạo ion kiềm Mitsubishi Cleansui EU301 là sản phẩm cao cấp từ Tập đoàn Mitsubishi Chemical Holdings (Nhật Bản), hiện đã được tin dùng tại hơn 40 quốc gia.
Với công suất lọc mạnh mẽ 8.000 lít, thiết bị cung cấp nguồn nước sạch dồi dào cho cả gia đình trong suốt 12 tháng, đảm bảo sự an toàn và ổn định lâu dài.
Sức mạnh của Mitsubishi Cleansui EU301 nằm ở công nghệ màng lọc sợi rỗng tiên tiến, giúp loại bỏ hiệu quả vi khuẩn, tạp chất siêu nhỏ nhưng vẫn giữ lại trọn vẹn khoáng chất tự nhiên cần thiết.
.jpg)
Nguồn nước đầu ra đạt chuẩn uống trực tiếp QCVN 6-1:2010/BYT với 6 chế độ linh hoạt (pH 5.0 - 10.5), đáp ứng mọi nhu cầu từ uống trực tiếp, nấu ăn đến chăm sóc sắc đẹp.
Sở hữu thiết kế hiện đại với vòi đồng mạ chrome sang trọng và bảng điều khiển trực quan, Mitsubishi Cleansui EU301 không chỉ nâng tầm không gian bếp mà còn vận hành cực kỳ bền bỉ nhờ hệ thống chống rò rỉ an toàn.
Hãy liên hệ ngay Siêu Thị Ion Kiềm để được tư vấn và chủ động bảo vệ sức khỏe gia đình bằng nguồn nước đạt chuẩn mỗi ngày.
---------------------
SIÊU THỊ ION KIỀM
0965401665